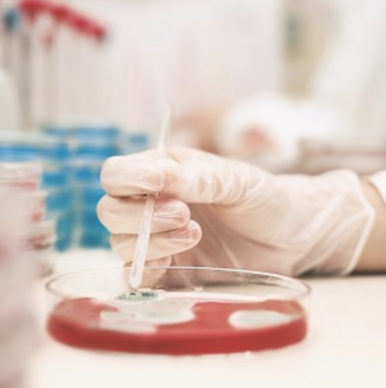

RI Ranked 3rd Worst State for Doctors in U.S.
GoLocalProv News Team
RI Ranked 3rd Worst State for Doctors in U.S.

Rhode Island is one of the worst states in the country for doctors. And, it may only get more complex for physicians in Rhode Island with a major hospital merger pending. Presently, the subsidiary of Partners HealthCare -- Brigham hospital has an application into the RI Department of Health to takeover Rhode Island's second largest hospital group Care New England.
According to a recent study completed by WalletHub, RI is ranked as the third worst state in the U.S. for doctors.
GET THE LATEST BREAKING NEWS HERE -- SIGN UP FOR GOLOCAL FREE DAILY EBLAST“Doctors are among the highest-paid and most educated professionals in the U.S. In fact, “physician” was the highest-paid job type in 2018, with a median base salary of over $195,000 and over 3,000 job openings during the year. The high salary average makes sense, given the importance of their life-saving work and the struggles that come with life in the medical profession,” said WalletHub.
In Rhode Island, physicians face a number of challenges tied to the cost of malpractice.
RI's Rankings
- 44th Best – Avg. Annual Wage of Physicians (Adjusted for Cost of Living)
- 23rd Best – Avg. Monthly Starting Salary of Physicians (Adjusted for Cost of Living)
- 48th Best – Hospitals per Capita
- 18th Best – Projected % of Population Aged 65 & Older by 2030
- 46th Best – Projected Physicians per Capita by 2026
- 32nd Best – Punitiveness of State Medical Board
- 50th Best– Malpractice Award Payout Amount per Capita
- 25th Best – Annual Malpractice Liability Insurance Rate
The Rankings
Rhode Island is ranked 49th, ahead of only District of Columbia and New York, who rank 50th and 51st overall.
RI is ranked behind Connecticut and New Jersey, who rank 47th and 48th respectively.
Montana is ranked as the best state for doctors.
See the Full Rankings in the Map Below
The Method
In order to identify the best states for doctors, WalletHub compared the 50 states and the District of Columbia across two key dimensions, “Opportunity & Competition” and “Medical Environment.”
They evaluated those dimensions using 18 relevant metrics, which are listed below with their corresponding weights.
WalletHub then determined each state and the District’s weighted average across all metrics to calculate its overall score and used the resulting scores to rank-order our sample.
Opportunity & Competition – Total Points: 70
- Physicians’ Average Annual Wage: Double Weight (~11.67 Points)
- Physicians’ Average Monthly Starting Salary: Full Weight (~5.83 Points)
- Hospitals per Capita: Full Weight (~5.83 Points)
- Insured Population Rate: Full Weight (~5.83 Points)
- Employer-Based Insurance Rate: Full Weight (~5.83 Points)
- Projected Share of Elderly Population: Full Weight (~5.83 Points)
- Current Competition: Full Weight (~5.83 Points)
- Share of Medical Residents Retained: Full Weight (~5.83 Points)
- Projected Competition: Full Weight (~5.83 Points)
- Number of CME Credits Required: Full Weight (~5.83 Points)
- Presence of Interstate Medical Licensure Compact Law: Full Weight (~5.83 Points)
Medical Environment – Total Points: 30
- Quality of Public Hospital System: Full Weight (~4.29 Points)
- Hospitals Safety - Percentage of “A” Hospitals: Full Weight (~4.29 Points)
- Presence of Nationally Accredited Health Departments: Full Weight (~4.29 Points)
- Physician Assistants per Capita: Full Weight (~4.29 Points)
- Punitiveness of State Medical Board: Full Weight (~4.29 Points)
- Malpractice Award Payout Amount per Capita: Full Weight (~4.29 Points)
- Annual Malpractice Liability Insurance Rate: Full Weight (~4.29 Points)